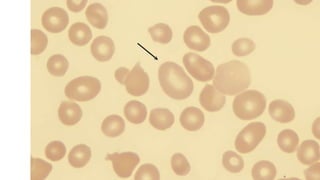

Este documento describe la anemia megaloblástica, causada por deficiencia de vitamina B12 o ácido fólico. Esto provoca una hematopoyesis defectuosa con producción anormal de células en la médula ósea y sangre llamadas megaloblastos. Los síntomas incluyen anemia, parestesias y glositis. El tratamiento consiste en suplementos intramusculares de vitamina B12 y/o ácido fólico.